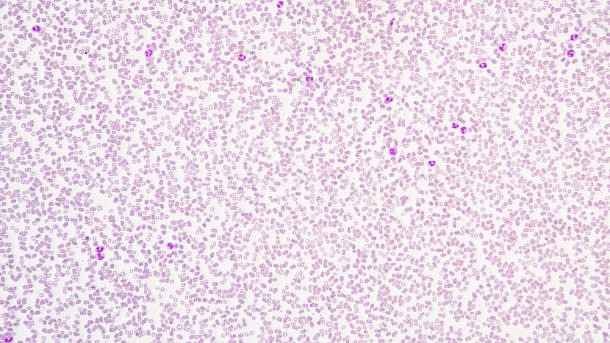

קיימות עדויות רבות המצביעות על הצורך במינונים גבוהים יותר של וונקומיצין לטיפול במטופלים נויטרופנים. על מנת להימנע מחשיפה למינון תת-טיפולי של התרופה, ישנה חשיבות אדירה להבין מה המינון הנכון כבר מהמנה הראשונה של הטיפול. מטרת המחקר הייתה לכמת את ההשפעה של נויטרופניה על הפרמקוקינטיקה של וונקומיצין.
החוקרים השתמשו במידע מתוך עוקבה מזווגת של מטופלים עם (1) מחלות המטולוגיות ידועות, (2) גידולים ממאירים סולידיים ו-(3) מטופלים ללא מחלה ממאירה מאובחנת. החוקרים ניתחו את הפרמקוקינטיקה באמצעות מודלים מעורבים לא ליניאריים, כאשר נויטרופניה נותחה כמשתנה בינארי ונבדקה ההשפעה על פינוי ונפח הפיזור של וונקומיצין.
במחקר נכללו 116 מטופלים (39 עם מחלות המטולוגיות, 39 עם ממאירויות סולידיות ו-38 מטופלים ללא אבחנה של ממאירות). באנליזה נכללו 742 תצפיות מזווגות של ריכוז תלוי זמן. תוצאות המחקר הראו כי נויטרופניה מעלה באופן מובהק (p= 0.00517) את הפינוי של וונקומיצין ב-27.7% (רווח בר סמך 95%: 10.2-46.2%), בזמן שלא נצפתה השפעה על נפח הפיזור (p= 0.704).
החוקרים הצליחו להראות שהפינוי של וונקומיצין מוגבר ב-27.7% בקרב מטופלים עם נויטרופניה. לכן, צריך להעלות את מנת האחזקה של וונקומיצין באופן פרמטי ב-25% במטופלים נויטרופנים בתחילת הטיפול. מכיוון שנראה כי אין השפעה על נפח הפיזור, אין צורך בביצוע התאמות במנת ההעמסה.
חשוב לציין כי ההתאמות הללו במינונים לא מבטלות את הצורך בהתאמה אישית של המינונים באמצעות ניטור ההשפעה הטיפולית של התרופה.
מקור:
Bury, D. et al. (2019) European Journal of Clinical Pharmacology 75,7
https://link.springer.com/article/10.1007/s00228-019-02657-6